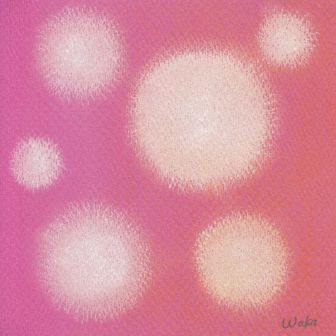

GALLERY
慈 -Affection-2017.12.16











慈 -Affection-2017.12.13











あなたが創る未来2017.12.12











あなたが創る未来の社会2017.12.8
















Challenge2017.11.22















怖 -Fear-2017.11.18







怖 -Fear-2017.11.15










挑戦 -Challenge-2017.10.28












あなたを突き動かすもの2017.10.26














挑戦 -Challenge-2017.10.25
























あなたが創る未来2017.10.15














あなたが創る未来2017.10.11

創造のエネルギー -Creative Energy-2017.9.20








創造のエネルギー -Creative Energy-2017.9.16














Challenge2017.9.6






















大切にしていること -What I value the most-2017.8.19








大切にしていること -What I value the most-2017.8.9














あなたが創る未来2017.8.3





















Change2017.8.2





















怒 -Anger-2017.7.22






怒 -Anger-2017.7.12











「変革リーダー・ラボ」が創り出す未来2017.6.27





成長 -Growth-2017.6.24








あなたにとっての学び2017.6.16











育 -Growth-2017.6.14














多様性の受容2017.6.6













望 -Wish-2017.5.20















望 -Wish-2017.5.17














望 -Wish-2017.5.10









源 -Origin-2017.4.22




源 -Origin-2017.4.19









源 -Origin-2017.4.12







2025年のありたい姿2017.3.31






















変 -Change-2017.3.18




変 -Change-2017.3.15







変 -Change-2017.3.8







歓 -Pleasure-2017.2.18







歓 -Pleasure-2017.2.15










歓 -Pleasure-2017.2.8






















2020年のありたい姿2017.1.28
























今年のわたし2017.1.21






今年のわたし2017.1.18























今年のわたし2017.1.14

























